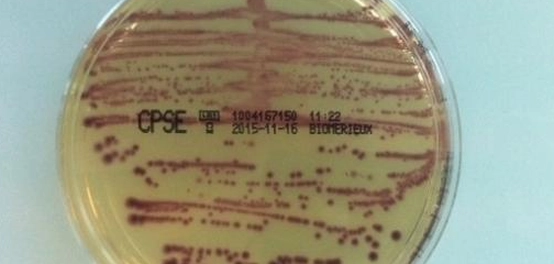

ما هو فحص زرع البول؟
يُعتبر فحص زرع البول (بالإنجليزية: Urine culture) إجراءً مختبرياً حيوياً يسهم في تحديد وجود أي عدوى في المسالك البولية. في أغلب الأحيان، تُجمع عينة البول في وعاء معقم مخصص. قد تتطلب بعض الحالات إدخال قسطرة بولية للوصول إلى المثانة للحصول على العينة المطلوبة. في حالات نادرة، قد يلجأ الطبيب إلى إدخال إبرة عبر البطن مباشرة لسحب عينة من المثانة. من المستحسن تجنب التبول لمدة ساعتين إلى ثلاث ساعات قبل جمع العينة، لضمان الحصول على نتيجة دقيقة.
هذا الفحص يساعد الأطباء على تشخيص التهابات المسالك البولية وتحديد نوع البكتيريا المسببة للالتهاب، مما يتيح وصف العلاج المناسب.
قال تعالى: ﴿وَيَسْأَلُونَكَ عَنِ الْمَحِيضِ قُلْ هُوَ أَذًى فَاعْتَزِلُوا النِّسَاءَ فِي الْمَحِيضِ وَلَا تَقْرَبُوهُنَّ حَتَّىٰ يَطْهُرْنَ ۖ فَإِذَا تَطَهَّرْنَ فَأْتُوهُنَّ مِنْ حَيْثُ أَمَرَكُمُ اللَّهُ ۚ إِنَّ اللَّهَ يُحِبُّ التَّوَّابِينَ وَيُحِبُّ الْمُتَطَهِّرِينَ﴾ [البقرة: 222].
مبررات إجراء فحص زرع البول
عادةً ما يُطلب إجراء فحص زرع البول عند الاشتباه بوجود عدوى في الجهاز البولي أو عند ظهور أعراض تشير إلى وجود التهاب، وقد يمتد الالتهاب إلى الكليتين. أيضاً، قد يُجرى هذا التحليل للمرأة الحامل خلال زيارتها الأولى للطبيب أو في الثلث الأول من الحمل، حتى في حال عدم ظهور أي أعراض للعدوى، وذلك للكشف المبكر عن وجود بكتيريا في البول، لما قد يؤثر ذلك على صحة الجنين.
تجدر الإشارة إلى أن فحص زرع البول لا يُجرى في جميع حالات عدوى الجهاز البولي، وإنما يُقتصر على الحالات التي لا تستجيب للعلاج بالمضادات الحيوية الموصوفة أو الحالات المعقدة.
عن أبي هريرة رضي الله عنه قال: قال رسول الله صلى الله عليه وسلم: «الطُّهُورُ شَطْرُ الإِيمَانِ، وَالحَمْدُ للهِ تَمْلأُ المِيزَانَ، وَسُبْحَانَ اللهِ وَالحَمْدُ للهِ تَمْلآنِ – أَوْ تَمْلأُ – مَا بَيْنَ السَّمَاوَاتِ وَالأَرْضِ، وَالصَّلاةُ نُورٌ، وَالصَّدَقَةُ بُرْهَانٌ، وَالصَّبْرُ ضِيَاءٌ، وَالقُرْآنُ حُجَّةٌ لَكَ أَوْ عَلَيْكَ. كُلُّ النَّاسِ يَغْدُو فَبَائِعٌ نَفْسَهُ فَمُعْتِقُهَا أَوْ مُوبِقُهَا». [رواه مسلم].
فهم نتائج فحص زرع البول
بعد إرسال عينة البول إلى المختبر، تُزرع في بيئة مناسبة لعدة أيام للسماح للبكتيريا أو أي كائنات دقيقة أخرى بالنمو. إذا ظهر عدد قليل من الكائنات الدقيقة، تعتبر النتيجة سلبية، أي لا يوجد التهاب. أما إذا ظهرت بكتيريا أو أنواع أخرى من الكائنات الدقيقة، فتعتبر النتيجة موجبة، مما يعني وجود عدوى.
يمكن من خلال هذا التحليل تحديد نوع البكتيريا المسببة للعدوى، إما عن طريق فحصها تحت المجهر أو عن طريق إجراء اختبار إضافي. وبناءً على النتائج، يحدد الطبيب العلاج المناسب.
يهدف هذا الفحص إلى تحديد ما إذا كان هناك نمو بكتيري في البول، وإذا كان الأمر كذلك، ما هو نوع البكتيريا الموجودة. وهذا يساعد الأطباء على اختيار المضاد الحيوي الأنسب لعلاج العدوى.